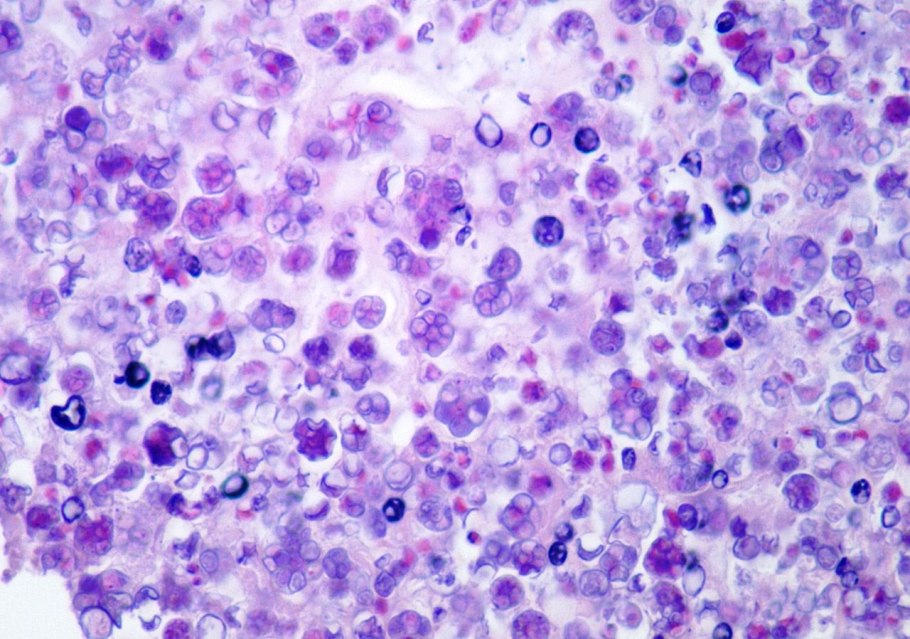

Зеленые водоросли заболевание у собак

Chlorophyta отдел зелёные водоросли

Phytophthora Cinnamomi

Ривулярия водоросль

Размножение и многообразие водорослей

Слизистые водоросли

Phacus caudatus водоросль

Galaxaura filamentosa водоросли

Глеотрихия водоросль

Зигнема водоросль в воде

Фукус водоросль под микроскопом

Клетка Oedogonium

Трихомы цианобактерий

Монострома водоросль

Rivularia bullata

Водоросль Эдогониум

Фотосинтезирующие цианобактерии

Водоросли в волосах

Фон желтый с водорослями рисунок

Аэрофильные водоросли

Ульва жгутики

Пальмеллоидный таллом

Эвглена зеленая водоросль

Водоросли паразиты

Синезеленые цианобактерии

Бактерий Shigella, Salmonella

Anabaena azollae

Anabaena azollae

Колония одноклеточных водорослей

Цианобактерии это фотосинтетики

Closterium strigosum

Хризофитовые водоросли

Цианобактерии в чашке Петри

Маримо водоросль

Spirogyra porticalis

Спирулина, хлорелла, эвглена польза

Электронасос el.Pal.cerpadlo-kompl 2070710034

Spirulina микроскоп

Леманея (lemanea)
Желто-зеленые водоросли - Xanthophyceae

Codium tomentosum

Кладофора водоросль под микроскопом

Синезеленые цианобактерии

ГЕМАТОКОКК дождевой

Arthrospira platensis

Энтероморфа водоросль











Поделиться фото в социальных сетях:
Комментариев (0)
Похожие фото:











